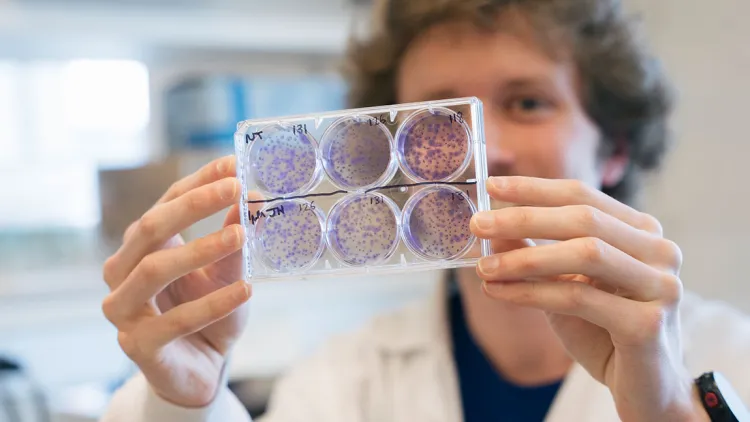
A student researcher holds up petri dishes in a lab

As the University of Vermont looks back on a fantastic year and looks forward to everything that’s ahead, we’re reflecting on just a few of our campus community’s favorite stories of the past year.

Learning On the Job
UVM students were in high demand this year, making an impact at companies and organizations across the state and getting real-world career experience. They took flight–and helped build cutting-edge planes, took full advantage of summer, trained for the green jobs of the future, and took home awards in international competitions. Across every area of study, UVM students excelled as they prepared for their futures.

Athletics: A Year for the Record Books
The 2021-2022 sports season was arguably the greatest in UVM Athletics history, and Catamount Country had a lot to cheer about. UVM teams achieved the university’s best-ever collective team winning percentage while maintaining a 3.4 GPA as a department.
Along the way, they racked up 10 conference regular season or tournament championships and placed second in the America East Commissioner’s Cup. A record 13 athletes represented UVM and five different countries in the 2022 Beijing Winter Olympics. A record six teams made it to NCAA championships, while Men’s Soccer repeated the feat this fall and advanced to the quarterfinals for the first time in over 30 years.
A Banner Year for Research
2021-2022 was one of the biggest years for research at UVM to date. Researchers continued to make and contribute to globally impactful discoveries: the world's oldest-known ice core; the ways ever-warming winters are threatening water quality; the toxic diet culture perpetuated by TikTok; healthcare advances made possible by an innovative sensor cloud network; and countless others.
A record number of UVM undergraduates earned prestigious Goldwater scholarships. Our researchers’ efforts didn't go unrecognized: UVM was named a Top 100 Public Research University by the National Science Foundation.

Recognizing Faculty and Staff
Faculty had plenty of moments to shine this year. They received awards from the Fulbright to the Guggenheim; they earned prestigious appointments, like the National Academies Board on Atmospheric Sciences and Climate; and they worked hard to eliminate the inequities in our world.

Moving Forward as a Campus Community
This year, time-honored UVM organizations carried on stronger than ever–like the student-run UVM Rescue, which celebrated its 50th anniversary. Or the Larner College of Medicine, the nation’s seventh-oldest medical school, which marked its bicentennial. In other ways, the university moved forward into the future: a new School of the Arts; a new cutting-edge medical research facility; and a new campus plan that will carry us through 2032. As a university, we committed to keeping UVM affordable and accessible for students and families from Vermont and across the nation.
